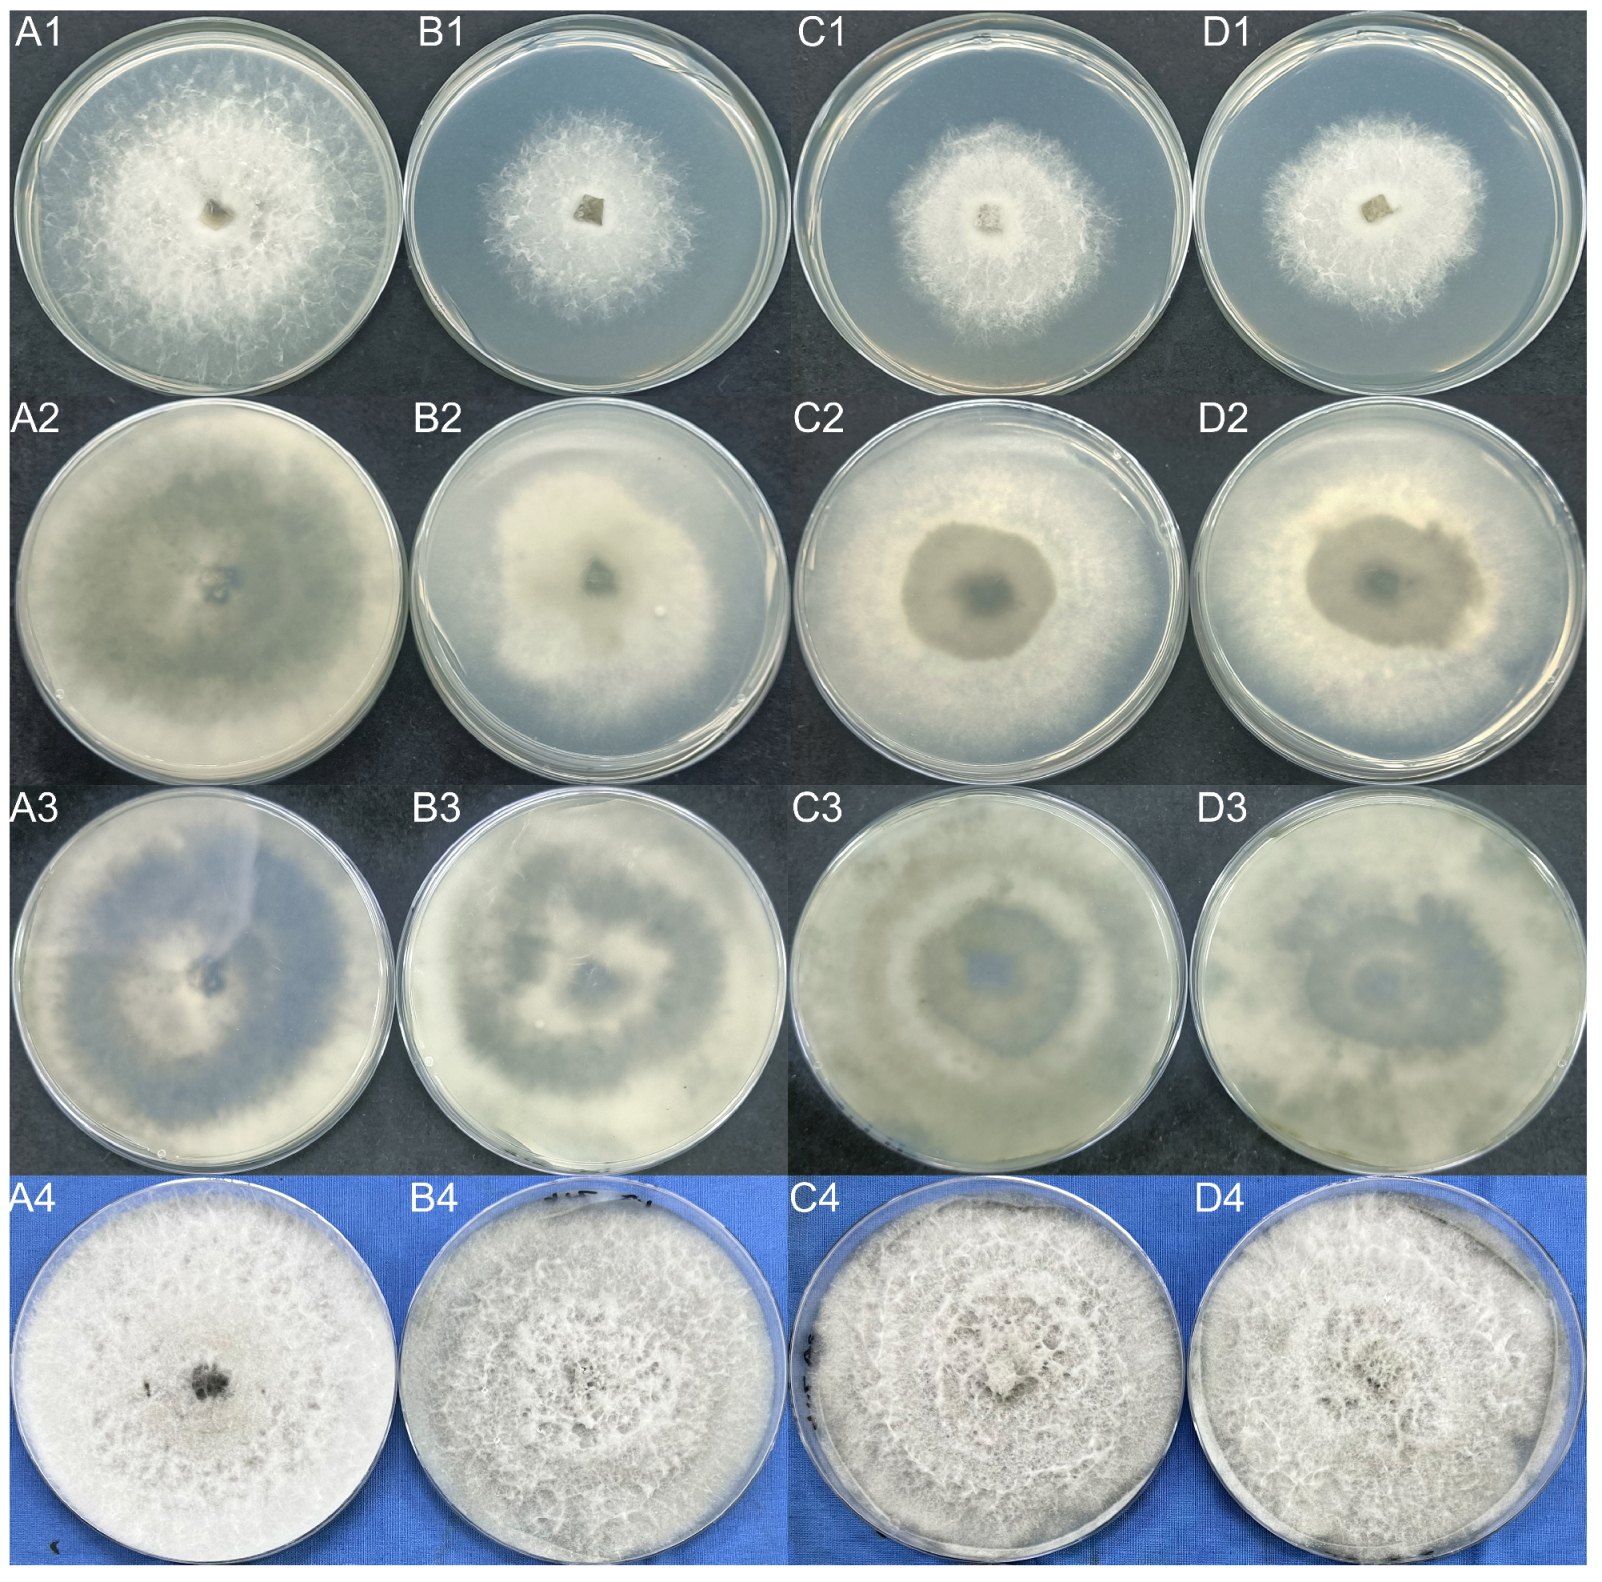
Ijms 23 09908 g012 550

Tandem Mass Tags Quantitative Proteome Identification and Function Analysis of ABC Transporters in Neofusicoccum parvum
Abstract
:1. Introduction
2. Results
2.1. Quantitative Proteomic Analysis
2.1.1. Proteomic Data Quality Control and Identification
2.1.2. Protein Function Annotation
2.1.3. Protein Quantification and Differential Analysis
2.1.4. Differentially Expressed Protein Enrichment Analysis
2.1.5. Subcellular Localization Analysis of DEPs
2.2. ABC Transporter Protein Analysis
Phylogenetic and Structural Analysis of ABC Transporter Proteins
2.3. Analysis of Protein-Protein Interaction (PPI) Network in ABC Transporters
2.4. Functional Validation of ABC Transporter Protein Genes
2.4.1. Determination of ABC Transporter Gene Expression by Quantitative Real-Time PCR (qRT-PCR)
2.4.2. Analysis of ABC2 Gene Structure
2.4.3. Knockout of the ABC2 Gene
2.4.4. Validation of the ABC2 Knockout Mutant
3. Discussion
4. Materials and Methods
4.1. Reagents, Equipment and Experimental Materials
4.2. Methods
4.2.1. Biological Material
4.2.2. Total Protein Extraction and Quality Testing
4.2.3. TMT Labeling of Peptides
4.2.4. Separation of Fractions and Liquid Chromatography Tandem Mass Spectrometry (LC-MS/MS) Analysis
4.2.5. Identification and Quantitation of Protein
4.2.6. Functional Analysis of Protein
4.2.7. GO and KEGG Enrichment Analysis of DEPs
4.2.8. Subcellular Localization Analysis of Differentially Expressed Proteins
4.2.9. Phylogenetic, Structural, and Functional Analysis of ABC Transporter Proteins in the Proteome
4.2.10. Analysis of PPI Network in ABC Transporters
4.2.11. The Determination of Expression Levels by qRT-PCR
4.2.12. Knockout Plasmid Construction
4.2.13. Protoplast Preparation and PEG-Mediated Protoplast Transformation
4.2.14. Phenotypic Analysis and the Determination of Sensitivity
4.2.15. Pathogenicity Testing
Supplementary Materials
Author Contributions
Funding
Institutional Review Board Statement
Informed Consent Statement
Data Availability Statement
Conflicts of Interest
References
- Dassa, E.; Bouige, P. The ABC of ABCs: A phylogenetic and functional classification of ABC systems in living organisms. Res. Microbiol. 2001, 152, 211–229. [Google Scholar] [CrossRef]
- Morita, M.; Imanaka, T. Peroxisomal ABC transporters: Structure, function and role in disease. Biochim. Biophys. Acta BBA Mol. Basis Dis. 2012, 1822, 1387–1396. [Google Scholar] [CrossRef] [PubMed]
- Beis, K. Structural basis for the mechanism of ABC transporters. Biochem. Soc. Trans. 2015, 43, 889–893. [Google Scholar] [CrossRef]
- Wilkens, S. Structure and mechanism of ABC transporters. F1000Prime Rep. 2015, 7, 14. [Google Scholar] [CrossRef]
- Hopfner, K.-P.; Karcher, A.; Shin, D.S.; Craig, L.; Arthur, L.M.; Carney, J.P.; Tainer, J.A. Structural Biology of Rad50 ATPase. Cell 2000, 101, 789–800. [Google Scholar] [CrossRef]
- Smith, P.C.; Karpowich, N.; Millen, L.; Moody, J.E.; Rosen, J.; Thomas, P.J.; Hunt, J.F. ATP Binding to the Motor Domain from an ABC Transporter Drives Formation of a Nucleotide Sandwich Dimer. Mol. Cell 2002, 10, 139–149. [Google Scholar] [CrossRef]
- Chen, J.; Lu, G.; Lin, J.; Davidson, A.L.; Quiocho, F.A. A Tweezers-like Motion of the ATP-Binding Cassette Dimer in an ABC Transport Cycle. Mol. Cell 2003, 12, 651–661. [Google Scholar] [CrossRef]
- Hollenstein, K.; Frei, D.C.; Locher, K.P. Structure of an ABC transporter in complex with its binding protein. Nature 2007, 446, 213–216. [Google Scholar] [CrossRef]
- Higgins, C.F.; Linton, K.J. The ATP switch model for ABC transporters. Nat. Struct. Mol. Biol. 2004, 11, 918–926. [Google Scholar] [CrossRef]
- Ter Beek, J.; Guskov, A.; Slotboom, D.J. Structural diversity of ABC transporters. J. Gen. Physiol. 2014, 143, 419–435. [Google Scholar] [CrossRef] [Green Version]
- Oldham, M.L.; Chen, J. Snapshots of the maltose transporter during ATP hydrolysis. Proc. Natl. Acad. Sci. USA 2011, 108, 15152–15156. [Google Scholar] [CrossRef] [PubMed]
- Lewinson, O.; Lee, A.T.; Locher, K.P.; Rees, D.C. A distinct mechanism for the ABC transporter BtuCD-BtuF revealed by the dynamics of complex formation. Nat. Struct. Mol. Biol. 2010, 17, 332–338. [Google Scholar] [CrossRef] [PubMed]
- Kim, Y.; Park, S.-Y.; Kim, D.; Choi, J.; Lee, Y.-H.; Lee, J.-H.; Choi, W. Genome-scale analysis of ABC transporter genes and characterization of the ABCC type transporter genes in Magnaporthe oryzae. Genomics 2013, 101, 354–361. [Google Scholar] [CrossRef] [PubMed]
- Urban, M.; Bhargava, T.; Hamer, J.E. An ATP-driven efflux pump is a novel pathogenicity factor in rice blast disease. EMBO J. 1999, 18, 512–521. [Google Scholar] [CrossRef] [PubMed]
- Gupta, A.; Chattoo, B.B. Functional analysis of a novel ABC transporter ABC4 fromMagnaporthe grisea. FEMS Microbiol. Lett. 2008, 278, 22–28. [Google Scholar] [CrossRef]
- Lee, Y.-J.; Yamamoto, K.; Hamamoto, H.; Nakaune, R.; Hibi, T. A novel ABC transporter gene ABC2 involved in multidrug susceptibility but not pathogenicity in rice blast fungus, Magnaporthe grisea. Pestic. Biochem. Physiol. 2005, 81, 13–23. [Google Scholar] [CrossRef]
- Sun, C.B.; Suresh, A.; Deng, Y.Z.; Naqvi, N.I. A Multidrug Resistance Transporter in Magnaporthe Is Required for Host Penetration and for Survival during Oxidative Stress. Plant Cell 2006, 18, 3686–3705. [Google Scholar] [CrossRef]
- Schoonbeek, H.; Del Sorbo, G.; De Waard, M.A. The ABC Transporter BcatrB Affects the Sensitivity ofBotrytis cinereato the Phytoalexin Resveratrol and the Fungicide Fenpiclonil. Mol. Plant Microbe Interact. 2001, 14, 562–571. [Google Scholar] [CrossRef]
- Stefanato, F.L.; Abou-Mansour, E.; Buchala, A.; Kretschmer, M.; Mosbach, A.; Hahn, M.; Bochet, C.G.; Métraux, J.-P.; Schoonbeek, H. The ABC transporter BcatrB fromBotrytis cinereaexports camalexin and is a virulence factor onArabidopsis thaliana. Plant J. 2009, 58, 499–510. [Google Scholar] [CrossRef]
- Hayashi, K.; Schoonbeek, H.; De Waard, M.A. Expression of the ABC transporter BcatrD from Botrytis cinerea reduces sensitivity to sterol demethylation inhibitor fungicides. Pestic. Biochem. Physiol. 2002, 73, 110–121. [Google Scholar] [CrossRef]
- Hayashi, K.; Schoonbeek, H.; Sugiura, H.; De Waard, M.A. Multidrug Resistance in Botrytis cinerea Associated with Decreased Accumulation of the Azole Fungicide Oxpoconazole and Increased Transcription of the ABC Transporter Gene BcatrD. Pestic. Biochem. Physiol. 2001, 70, 168–179. [Google Scholar] [CrossRef]
- Vermeulen, T.; Schoonbeek, H.; De Waard, M.A. The ABC transporter BcatrB fromBotrytis cinerea is a determinant of the activity of the phenylpyrrole fungicide fludioxonil. Pest Manag. Sci. 2001, 57, 393–402. [Google Scholar] [CrossRef] [PubMed]
- Schoonbeek, H.; van Nistelrooy, J.G.M.; de Waard, M.A. Functional Analysis of ABC Transporter Genes FromBotrytis cinereaIdentifies BcatrB as a Transporter of Eugenol. Eur. J. Plant Pathol. 2003, 109, 1003–1011. [Google Scholar] [CrossRef]
- Úrbez-Torres, J.R.; Gubler, W.D. Susceptibility of grapevine pruning wound to infection by Lasiodiplodia theobromae and Neofusicoccum parvum. Plant Pathol. 2011, 60, 261–270. [Google Scholar] [CrossRef]
- Espinoza, J.G.; Briceño, E.X.; Chávez, E.R.; Úrbez-Torres, J.R.; Latorre, B.A. Neofusicoccum spp. associated with stem canker and dieback of blueberry in Chile. Plant Dis. 2009, 93, 1187–1194. [Google Scholar] [CrossRef] [PubMed]
- Javier-Alva, J.; Gramaje, D.; Alvarez, L.A.; Armengol, J. First Report of Neofusicoccum parvum Associated with Dieback of Mango Trees in Peru. Plant Dis. 2009, 93, 426. [Google Scholar] [CrossRef]
- Zhou, Y.; Gong, G.; Cui, Y.; Zhang, D.; Chang, X.; Hu, R.; Liu, N.; Sun, X. Identification of Botryosphaeriaceae Species Causing Kiwifruit Rot in Sichuan Province, China. Plant Dis. 2015, 99, 699–708. [Google Scholar] [CrossRef]
- Zea-Bonilla, T.; González-Sánchez, M.A.; Martín-Sánchez, P.M.; Pérez-Jiménez, R.M. Avocado Dieback Caused by Neofusicoccum parvum in the Andalucia Region, Spain. Plant Dis. 2007, 91, 1052. [Google Scholar] [CrossRef]
- KC, A.N.; Vallad, G.E. First Report of Neofusicoccum parvum Causing Shoot Blight and Stem Cankers on Pomegranate in Florida. Plant Dis. 2016, 100, 1783. [Google Scholar] [CrossRef]
- Jeff-Ego, O.S.; Akinsanmi, O.A. Botryosphaeriaceae causing branch dieback and tree death of macadamia in Australia. Australas. Plant Pathol. 2018, 48, 59–64. [Google Scholar] [CrossRef]
- Lazzizera, C.; Frisullo, S.; Alves, A.; Phillips, A.J.L. Morphology, phylogeny and pathogenicity of Botryosphaeria and Neofusicoccum species associated with drupe rot of olives in southern Italy. Plant Pathol. 2008, 57, 948–956. [Google Scholar] [CrossRef]
- Chen, J.; Han, S.; Li, S.; Wang, M.; Zhu, H.; Qiao, T.; Lin, T.; Zhu, T. Comparative Transcriptomics and Gene Knockout Reveal Virulence Factors of Neofusicoccum parvum in Walnut. Front. Microbiol. 2020, 13, 926620. [Google Scholar] [CrossRef] [PubMed]
- Massonnet, M.; Morales-Cruz, A.; Figueroa-Balderas, R.; Lawrence, D.P.; Baumgartner, K.; Cantu, D. Condition-dependent co-regulation of genomic clusters of virulence factors in the grapevine trunk pathogen Neofusicoccum parvum. Mol. Plant Pathol. 2018, 19, 21–34. [Google Scholar] [CrossRef] [PubMed]
- Ma, J.; Chen, T.; Wu, S.; Yang, C.; Bai, M.; Shu, K.; Li, K.; Zhang, G.; Jin, Z.; He, F.; et al. iProX: An integrated proteome resource. Nucleic Acids Res. 2019, 47, D1211–D1217. [Google Scholar] [CrossRef]
- Kumari, S.; Kumar, M.; Khandelwal, N.K.; Kumari, P.; Varma, M.; Vishwakarma, P.; Shahi, G.; Sharma, S.; Lynn, A.M.; Prasad, R.; et al. ABC transportome inventory of human pathogenic yeast Candida glabrata: Phylogenetic and expression analysis. PLoS ONE 2018, 13, e0202993. [Google Scholar] [CrossRef]
- Verrier, P.J.; Bird, D.; Burla, B.; Dassa, E.; Forestier, C.; Geisler, M.; Klein, M.; Kolukisaoglu, U.; Lee, Y.; Martinoia, E.; et al. Plant ABC proteins—A unified nomenclature and updated inventory. Trends Plant Sci. 2008, 13, 151–159. [Google Scholar] [CrossRef]
- Beers, M.F.; Mulugeta, S. The biology of the ABCA3 lipid transporter in lung health and disease. Cell Tissue Res. 2017, 367, 481–493. [Google Scholar] [CrossRef]
- Peelman, F.; Labeur, C.; Vanloo, B.; Roosbeek, S.; Devaud, C.; Duverger, N.; Denèfle, P.; Rosier, M.; Vandekerckhove, J.; Rosseneu, M. Characterization of the ABCA Transporter Subfamily: Identification of Prokaryotic and Eukaryotic Members, Phylogeny and Topology. J. Mol. Biol. 2003, 325, 259–274. [Google Scholar] [CrossRef]
- Favell, G.; McNeil, J.N.; Donly, C. The ABCB Multidrug Resistance Proteins Do Not Contribute to Ivermectin Detoxification in the Colorado Potato Beetle, Leptinotarsa decemlineata (Say). Insects 2020, 11, 135. [Google Scholar] [CrossRef]
- Saito, S.; Iida, A.; Sekine, A.; Miura, Y.; Ogawa, C.; Kawauchi, S.; Higuchi, S.; Nakamura, Y. Three hundred twenty-six genetic variations in genes encoding nine members of ATP-binding cassette, subfamily B (ABCB/MDR/TAP), in the Japanese population. J. Hum. Genet. 2002, 47, 38–50. [Google Scholar] [CrossRef]
- Sturm, A.; Cunningham, P.; Dean, M. The ABC transporter gene family of Daphnia pulex. BMC Genom. 2009, 10, 170. [Google Scholar] [CrossRef] [PubMed]
- Xu, Y.; Zhang, S.; Guo, H.; Wang, S.; Xu, L.; Li, C.; Qian, Q.; Chen, F.; Geisler, M.; Qi, Y.; et al. OsABCB14 functions in auxin transport and iron homeostasis in rice (Oryza sativa L.). Plant J. 2014, 79, 106–117. [Google Scholar] [CrossRef]
- Kamimoto, Y.; Terasaka, K.; Hamamoto, M.; Takanashi, K.; Fukuda, S.; Shitan, N.; Sugiyama, A.; Suzuki, H.; Shibata, D.; Wang, B.; et al. Arabidopsis ABCB21 is a Facultative Auxin Importer/Exporter Regulated by Cytoplasmic Auxin Concentration. Plant Cell Physiol. 2012, 53, 2090–2100. [Google Scholar] [CrossRef] [PubMed]
- Kovalchuk, A.; Driessen, A.J.M. Phylogenetic analysis of fungal ABC transporters. BMC Genom. 2010, 11, 177. [Google Scholar] [CrossRef]
- Paumi, C.M.; Chuk, M.; Snider, J.; Stagljar, I.; Michaelis, S. ABC Transporters in Saccharomyces cerevisiae and Their Interactors: New Technology Advances the Biology of the ABCC (MRP) Subfamily. Microbiol. Mol. Biol. Rev. 2009, 73, 577–593. [Google Scholar] [CrossRef] [PubMed]
- Eilers, M.; Roy, U.; Mondal, D. MRP (ABCC) Transporters-Mediated Efflux of Anti-HIV Drugs, Saquinavir and Zidovudine, from Human Endothelial Cells. Exp. Biol. Med. 2008, 233, 1149–1160. [Google Scholar] [CrossRef]
- Klein, M.; Burla, B.; Martinoia, E. The multidrug resistance-associated protein (MRP/ABCC) subfamily of ATP-binding cassette transporters in plants. FEBS Lett. 2006, 580, 1112–1122. [Google Scholar] [CrossRef]
- Ballatori, N.; Hammond, C.L.; Cunningham, J.B.; Krance, S.M.; Marchan, R. Molecular mechanisms of reduced glutathione transport: Role of the MRP/CFTR/ABCC and OATP/SLC21A families of membrane proteins. Toxicol. Appl. Pharmacol. 2005, 204, 238–255. [Google Scholar] [CrossRef]
- Khandelwal, N.K.; Wasi, M.; Nair, R.; Gupta, M.; Kumar, M.; Mondal, A.K.; Gaur, N.A.; Prasad, R. Vacuolar sequestration of azoles: A novel strategy of azole antifungal resistance conserved across pathogenic and non-pathogenic yeast. Antimicrob. Agents Chemother. 2019, 63, e01347-18. [Google Scholar] [CrossRef]
- De Marcos Lousa, C.; van Roermund, C.W.T.; Postis, V.L.G.; Dietrich, D.; Kerr, I.D.; Wanders, R.J.A.; Baldwin, S.A.; Baker, A.; Theodoulou, F.L. Intrinsic acyl-CoA thioesterase activity of a peroxisomal ATP binding cassette transporter is required for transport and metabolism of fatty acids. Proc. Natl. Acad. Sci. USA 2013, 110, 1279–1284. [Google Scholar] [CrossRef] [Green Version]
- Van Roermund, C.W.T.; IJlst, L.; Wagemans, T.; Wanders, R.J.A.; Waterham, H.R. A role for the human peroxisomal half-transporter ABCD3 in the oxidation of dicarboxylic acids. Biochim. Biophys. Acta BBA Mol. Cell Biol. Lipids 2014, 1841, 563–568. [Google Scholar] [CrossRef] [PubMed]
- Hettema, E.H.; van Roermund, C.W.; Distel, B.; van den Berg, M.; Vilela, C.; Rodrigues-Pousada, C.; Wanders, R.J.; Tabak, H.F. The ABC transporter proteins Pat1 and Pat2 are required for import of long-chain fatty acids into peroxisomes of Saccharomyces cerevisiae. EMBO J. 1996, 15, 3813–3822. [Google Scholar] [CrossRef] [PubMed]
- Kerr, I.D. Sequence analysis of twin ATP binding cassette proteins involved in translational control, antibiotic resistance, and ribonuclease L inhibition. Biochem. Biophys. Res. Commun. 2004, 315, 166–173. [Google Scholar] [CrossRef] [PubMed]
- Coleman, J.J.; Mylonakis, E. Efflux in Fungi: La Pièce de Résistance. PLoS Pathog. 2009, 5, e1000486. [Google Scholar] [CrossRef] [PubMed]
- Schmitz, G.; Langmann, T.; Heimerl, S. Role of ABCG1 and other ABCG family members in lipid metabolism. J. Lipid Res. 2001, 42, 1513–1520. [Google Scholar] [CrossRef]
- Kusuhara, H.; Sugiyama, Y. ATP-binding cassette, subfamily G (ABCG family). Pflügers Arch. Eur. J. Physiol. 2007, 453, 735–744. [Google Scholar] [CrossRef]
- Jungwirth, H.; Kuchler, K. Yeast ABC transporters—A tale of sex, stress, drugs and aging. FEBS Lett. 2006, 580, 1131–1138. [Google Scholar] [CrossRef]
- Balzi, E.; Goffeau, A. Yeast multidrug resistance: The PDR network. J. Bioenerg. Biomembr. 1995, 27, 71–76. [Google Scholar] [CrossRef]
- Hlaváček, O.; Kučerová, H.; Harant, K.; Palková, Z.; Váchová, L. Putative role for ABC multidrug exporters in yeast quorum sensing. FEBS Lett. 2009, 583, 1107–1113. [Google Scholar] [CrossRef]
- Wilcox, L.J.; Balderes, D.A.; Wharton, B.; Tinkelenberg, A.H.; Rao, G.; Sturley, S.L. Transcriptional Profiling Identifies Two Members of the ATP-binding Cassette Transporter Superfamily Required for Sterol Uptake in Yeast. J. Biol. Chem. 2002, 277, 32466–32472. [Google Scholar] [CrossRef] [Green Version]
- Koonin, E.V.; Fedorova, N.D.; Jackson, J.D.; Jacobs, A.R.; Krylov, D.M.; Makarova, K.S.; Mazumder, R.; Mekhedov, S.L.; Nikolskaya, A.N.; Rao, B.S.; et al. A comprehensive evolutionary classification of proteins encoded in complete eukaryotic genomes. Genome biol. 2004, 5, R7. [Google Scholar] [CrossRef] [PubMed]
- Andrade, A.E.; Silva, L.P.; Pereira, J.L.; Noronha, E.F.; Reis, J.F.B.; Bloch, Jr.; Dos Santos, M.F.; Domont, G.B.; Franco, O.L.; Mehta, A. In vivo proteome analysis of Xanthomonas campestris pv. campestris in the interaction with the host plant Brassica oleracea. FEMS Microbiol. Lett. 2008, 281, 167–174. [Google Scholar] [CrossRef]
- Morales-Cruz, A.; Amrine, K.C.H.; Blanco-Ulate, B.; Lawrence, D.P.; Travadon, R.; Rolshausen, P.E.; Baumgartner, K.; Cantu, D. Distinctive expansion of gene families associated with plant cell wall degradation, secondary metabolism, and nutrient uptake in the genomes of grapevine trunk pathogens. BMC Genom. 2015, 16, 469. [Google Scholar] [CrossRef] [PubMed]
- Jones, P.; Binns, D.; Chang, H.-Y.; Fraser, M.; Li, W.; McAnulla, C.; McWilliam, H.; Maslen, J.; Mitchell, A.; Nuka, G.; et al. InterProScan 5: Genome-scale protein function classification. Bioinformatics 2014, 30, 1236–1240. [Google Scholar] [CrossRef] [PubMed]
- Huang, D.W.; Sherman, B.T.; Lempicki, R.A. Bioinformatics enrichment tools: Paths toward the comprehensive functional analysis of large gene lists. Nucleic Acids Res. 2009, 37, 1–13. [Google Scholar] [CrossRef] [PubMed]
- Tamura, K.; Dudley, J.; Nei, M.; Kumar, S. MEGA4: Molecular Evolutionary Genetics Analysis (MEGA) software version 4.0. Mol. Biol. Evol. 2007, 24, 1596–1599. [Google Scholar] [CrossRef]
- Myung, I.J. Tutorial on maximum likelihood estimation. J. Math. Psychol. 2003, 47, 90–100. [Google Scholar] [CrossRef]
- Franceschini, A.; Szklarczyk, D.; Frankild, S.; Kuhn, M.; Simonovic, M.; Roth, A.; Lin, J.; Minguez, P.; Bork, P.; von Mering, C.; et al. STRING v9.1: Protein-protein interaction networks, with increased coverage and integration. Nucleic Acids Res. 2013, 41, D808–D815. [Google Scholar] [CrossRef]
- Livak, K.J.; Schmittgen, T.D. Analysis of relative gene expression data usingreal-time quantitative PCR and the 2−∆∆Ct method. Methods 2001, 25, 402–408. [Google Scholar] [CrossRef]
- Horton, R.M.; Hunt, H.D.; Ho, S.N.; Pullen, J.K.; Pease, L.R. Engineering hybrid genes without the use of restriction enzymes: Gene splicing by overlap extension. Gene 1989, 77, 61–68. [Google Scholar] [CrossRef]
- Islam, M.S.; Ali, M.; Ahmad, I. Efficacy of sedomil 72WP and recozeb 80WP to control die-back (Colletotrichum gloeosporioides) of tea in Bangladesh. J. Plant Prot. Sci. 2012, 4, 25–31. [Google Scholar]

| Item | Value |
|---|---|
| Type of Quantification | Reporter Quantification (TMT) |
| Enzyme | Trypsin |
| Max/Missed Cleavage Sites | 2 |
| Precursor Mass Tolerance | 10 ppm |
| Fragment Mass Tolerance | 0.02 Da |
| Dynamic Modification | Oxidation/+15.995 Da (M) and TMT/+229.163 Da (K,Y) |
| N-Terminal Modification | Acetyl/+42.011 Da (N-Terminal) and Met-loss/−131.040Da(M) and Met-loss+Acetyl/−89.030 Da(M) |
| Static Modification | Carbamidomethyl/+57.021 Da (C) |
Publisher’s Note: MDPI stays neutral with regard to jurisdictional claims in published maps and institutional affiliations. |
© 2022 by the authors. Licensee MDPI, Basel, Switzerland. This article is an open access article distributed under the terms and conditions of the Creative Commons Attribution (CC BY) license (https://creativecommons.org/licenses/by/4.0/).
Share and Cite
Chen, J.; Han, S.; Li, S.; Zhu, H.; Li, S.; Yan, J.; Zhu, T. Tandem Mass Tags Quantitative Proteome Identification and Function Analysis of ABC Transporters in Neofusicoccum parvum. Int. J. Mol. Sci. 2022, 23, 9908. https://doi.org/10.3390/ijms23179908
Chen J, Han S, Li S, Zhu H, Li S, Yan J, Zhu T. Tandem Mass Tags Quantitative Proteome Identification and Function Analysis of ABC Transporters in Neofusicoccum parvum. International Journal of Molecular Sciences. 2022; 23(17):9908. https://doi.org/10.3390/ijms23179908
Chicago/Turabian StyleChen, Jie, Shan Han, Shujiang Li, Hanmingyue Zhu, Shuying Li, Junjie Yan, and Tianhui Zhu. 2022. "Tandem Mass Tags Quantitative Proteome Identification and Function Analysis of ABC Transporters in Neofusicoccum parvum" International Journal of Molecular Sciences 23, no. 17: 9908. https://doi.org/10.3390/ijms23179908
APA StyleChen, J., Han, S., Li, S., Zhu, H., Li, S., Yan, J., & Zhu, T. (2022). Tandem Mass Tags Quantitative Proteome Identification and Function Analysis of ABC Transporters in Neofusicoccum parvum. International Journal of Molecular Sciences, 23(17), 9908. https://doi.org/10.3390/ijms23179908

